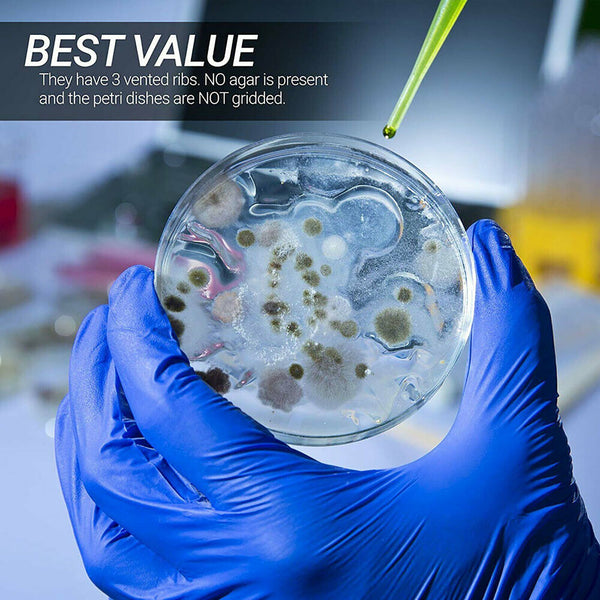
40PCS Plastic Petri dishes with lid 90x15mm Pre-sterile Polystyrene New AU

Description:
-100% brand new and high quality
-Laboratory analysis for medical, biological, scientific research and other activities, suitable for generaltraining.Transparent,convenient,firm,use efficiency.
Features:
-Culture For fungi, bacteria, and other microorganisms
-Used in the surface smooth and highly uniform, automatic dispenser can be a good implementation of the operation
-Deep hole bacteria culture dish allows longer incubation period
-Material:Polystyrene
-Size : Diameter 90 mm x Height 15 mm
-Package includes:
40PCS Petri Dishes
Notes:
Due to the light and screen setting difference, the item's colour may be slightly difference from the pictures.
Please allow slight dimension difference due to difference manual measurement.